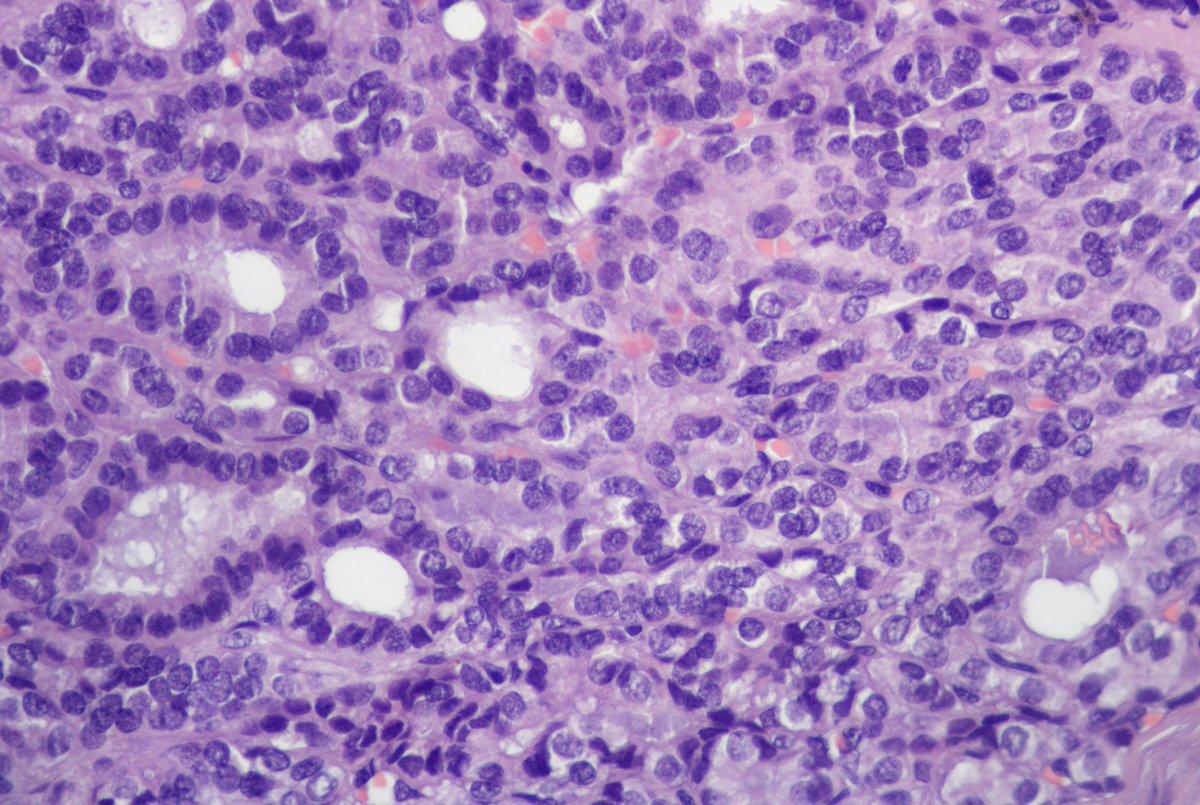
Аndrew tweet media

F40y,chronic cavitary pulmonary aspergillosis, atypical resection of the low lobe of the lung.
several cavities with a fungal ball, granulation tissue, chronic inflamation, metaplastic squamous epithelium, calcium oxalate crystals
#pulmpath #grosspath #aspergillosis #pathoutpic




English